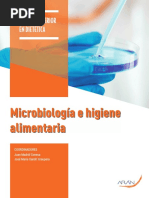

Mona de Pascua 2020
by www.esterroelas.com
Receta para dos tartas de 16cm de diámetro x 4cm de alto
Usaremos tres aros, para el interior uno de 14cm de diámetro, para la base de galleta uno de
15cm de diámetro, y para el montaje final uno de 16cm de diámetro. Deben ser aros de acero
inoxidable y rígidos. También usaremos rodoid o tira de acetato para forrar el aro del
montaje para después poder desmoldar fácilmente la tarta.
*Todos estos materiales los podéis encontrar en Reinoxsa, los fabrican ellos mismos y son muy
baratos. Además envían online.
ESTERROELAS.COM !1
�Primero hacemos el interior (en aro de 14cm de diámetro)
Para la compota de fresas con vinagre:
250g fresas cortadas a dados
20g vinagre de módena o de Jerez
120g azúcar
5g pectina NH
20g zumo de limón
-Maceramos las fresas con el vinagre y 50g del azúcar, mínimo media hora.
-Juntamos el resto de azúcar con la pectina, encapsulamos bien (remover).
-Calentamos las fresas y el vinagre a 40ºC, agregamos la pectina con el azúcar en forma de
lluvia, sin parar de remover.
-Llevamos a hervor y lo mantenemos un minuto. Agregamos el jugo de limón.
-Colocamos una capa de un centímetro de grosor en el aro de 14cm de diámetro.
-Congelamos.
Para la crema de vainilla:
250g nata
media vaina de vainilla fresca (intentar usar de la máxima calidad posible)
60g yema de huevo
50g azúcar
2,5g gelatina en polvo (o una hoja de gelatina), hidratada en 10g de agua fría
-A la medida de lo posible, intentaremos hacer una infusión larga de la vainilla con la nata,
mi consejo es hacer una infusión en frío, es decir, raspar la vaina y dejarla en la nata, en un
cuenco tapado con film, mínimo una noche entera.
-Hervir la nata infusionada con el azúcar, volcar encima de las yemas, sin parar de remover.
-Fundir la gelatina hidratada en el microondas, agregar a la mezcla.
-Colocar una capa de un centímetro, encima de la compota de fresas que deberá estar ya
congelada.
-Congelar.
ESTERROELAS.COM !2
�Para el bizcocho:
225g clara
125g azúcar
110g azúcar glace
160g almendra molida
50g harina floja
75g clara
25g nata 35% MG
-Montar los 225g de clara, agregar el azúcar en tres veces.
-Mientras, en un cuenco, juntar el azúcar glace, la almendra y la harina. Agregar los 75g de
clara y la nata, formando como un mazapán.
-Agregar el merengue al mazapán, en dos o tres veces.
-Extender en bandeja con silpat (o papel de horno).
-Hornear a 180ºC, unos 15 minutos, hasta que esté doradito y cuando apretemos ligeramente
con la yema del dedo, se hunda pero vuelva a subir.
-Dejamos enfriar, troquelamos con un aro de 14cm de diámetro. Colocamos encima de la
crema de vainilla, que deberá estar congelada.
-Congelamos.
Hacemos el sablée de caramelo (en aro de 15cm de diámetro):
120g mantequilla salada, cortada a dados, a temperatura ambiente (blanda)
60g azúcar glace
30g caramelo seco, triturado (hacemos caramelo, lo dejamos enfriar, lo trituramos fino con un
robot de cocina).
30g almendra en polvo
50g huevo
250g harina floja
-Mezclamos, lo justo para incorporar (a mano, o si lo hacemos en robot, con la pala a
velocidad mínima), la mantequilla con el azúcar glace y el caramelo en polvo.
-Agregamos la harina de almendra, a continuación el huevo y finalmente la harina tamizada.
-Extendemos entre hojas de papel de horno, 3mm de grosor. Congelamos.
ESTERROELAS.COM !3
�-Troquelamos con aro de 15cm de diámetro.
-Horneamos, encima de silpain, 155ºC, 15minutos.
-Reservar.
Montaje del pastel (en aro de 16cm de diámetro):
Hacemos la mousse de mascarpone:
375g mascarpone (elegir de la mejor calidad posible, que sea bien cremoso)
375g nata semi montada
60g yema de huevo
150g azúcar
50g agua
5g gelatina en polvo (o 2’5 hojas) hidratada en 20g agua fría.
-Calentamos el mascarpone a 23ºC.
-En un cazo, calentar el azúcar con el agua a 117ºC, volcar encima de las yemas que deberán
estar montando en la batidora. Batir hasta entibiar. (Pasta bomba).
-Fundir la gelatina hidratada en el micro, agregar a las yemas montadas.
-Agregar la pasta bomba al mascarpone, en movimientos envolventes.
-Finalmente, agregar la nata, también en movimientos envolventes.
-Poner un poco de mousse en aro de 16cm de diámetro, forrado con rodoid, colocar encima
de bandeja con hoja de guitarra (o si no tenemos, tapete de silicona).
-Colocar el interior (compuesto por la compota, la crema, el bizcocho).
-Poner un poco mas de mousse. Terminar con el sablée.
(Ver vídeo del montaje en mi instagram).
-Congelar, procurar que esté lo máximo de recto en el congelador.
Hacemos el glaseado:
66g agua
130g azúcar
4 hojas de gelatina hidratadas en agua fría
83g leche condensada
130g chocolate blanco (yo usé Ivoire de Valrhona)
ESTERROELAS.COM !4
�-Hervir el agua con el azúcar y la glucosa.
-Volcar encima del chocolate, la leche condensada y la gelatina hidratada y escurrida.
-Triturar con el túrmix, sacando el máximo de burbujas posible.
-Dejar enfriar a 40ºC.
-Desmoldar la tarta dándole un golpe seco encima de una tabla. Sacar el rodoid.
-Colocar la tarta encima de una reja, volcar el glaseado encima de la tarta, pasar espátula,
para sacar el exceso de glaseado, ya que si no, resultaría muy dulce.
-Decoramos al gusto, yo hice mini huevos de pascua con un molde de poli carbonato (tenéis
todo sobre la técnica de moldeado y bombones en el ebook de bombones), que también
encontraréis en reinoxsa, y hice una corona de hilos de chocolate blanco, la técnica es bien
sencilla, fundimos chocolate, no hace falta atemperar, ponemos en manga pastelera, vamos
haciendo hilos, encima de una bandeja de acero congelada (yo pongo varias al congelador la
noche anterior), antes de que se cristalice del todo el chocolate, de damos forma de corona,
dejamos cristalizar.
*Dejar descongelar en nevera mínimo 4 horas, antes de consumir, dejar 15 minutos a
temperatura ambiente.
*Se puede conservar congelada glaseada sin la decoración, hasta 15 días, el glaseado seguirá
brillando, pero recordar, cuanto mas fresco todo, mucho mas excelente el producto final.
ESTERROELAS.COM !5
�ESTERROELAS.COM !6